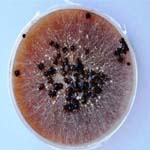

|
இலையுறை கருகல் நோய்
| ||||||||||||||||||||||||||||||||||||||||||||||||||||||||||||||||||||||||
| தாக்குதலின் அறிகுறிகள்: | ||
|
 இலையுறையின் மீது நீள்வட்ட (அ) ஒழுங்கற்ற பச்சை கலந்த சாம்பல் நிற புள்ளிகள் காணப்படும் |
 நீர் மட்டத்திற்கு அருகில் இலையுறை கருகி காணப்படும் |
 கருகிய இலையுறை |
 நிறமாற்றமாகிய இலையுறை |
|
| மேலே செல்க | ||
| நோய்க்காரணி: | ||
ரைசோக்டினியாவின் பூசண வளர்ச்சி |
 ரைசோக்டினியா சொலானி |
இலைக்கருகல் நோய்க்கு ஏற்ற காரணிகள்:
நோய் பரவும் விதம் மற்றும் நீடித்திருக்கும் தன்மை:
|
 இலையுறை கருகல் நோய்க்காரணி |
 ரைசோக்டினியா சொலானியின் ஆரம்ப பூசண வளர்ச்சி |
|
| மேலே செல்க | ||
| கட்டுப்பாடு முறைகள்: | ||
பாதுகாப்பு முறை:
|
 |
 |
| சூடோமோனஸ் உடன் தொழு உரம் கலந்து இடவும் | சூடோமோனஸ் உடன் விதை நேர்த்தி | |
உழவியல் முறை:
|
 |
 |
| கரிம நில சீர்திருத்திகளை இடவும் | ஆழமாக கோடை உழவு செய்யவும் | |
இராசயன முறை:
|
 |
 |
| ஐப்ரோடியோன் தெளிக்கவும் | பாலிஆக்ஸின் உயிர் கொல்லி மருந்து பயன்படுத்தவும் | |
| மேலே செல்க | ||
